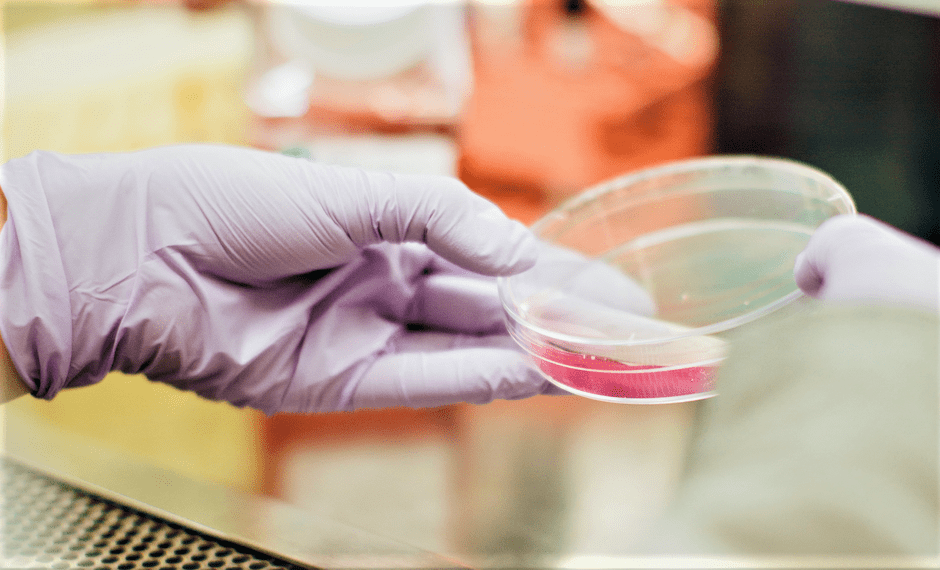

NOTICIAS INTERNACIONALES
José Donato Rodríguez Romero
(Compilador)
El secretario general del Consejo Mundial de Iglesias nombrado obispo primado de la Iglesia de Noruega
FUENTE: CMI. Oslo, Noruega. Enero 31, 2020. El 30 de enero, el Consejo de la Iglesia de Noruega nombró al secretario general del Consejo Mundial de Iglesias (CMI), el Rev. Dr. Olav Fykse Tveit, nuevo obispo primado de la Iglesia de Noruega.
Entre los doce obispos, el obispo primado es “el primero entre iguales” (primus inter pares). Él o ella es inquilino de la Conferencia Episcopal. El obispo primado es el responsable de la catedral de Nidaros junto con el obispo de la diócesis de Nidaros.
El Rev. Tveit dijo estar deseando volver a Trøndelag, donde pasó buena parte de su infancia.
“Un obispo debe escuchar a los demás, a la vez que unificar y aglutinar la diversidad de nuestra iglesia bajo nuestra fe común”, dijo Tveit. “Un obispo primado tiene la responsabilidad concreta de representar a toda la iglesia, además de ser una figura pública. Eso implica que, a veces, difundir el propio mensaje favorablemente es más importante que dominar el debate o decir la última palabra”, afirma el nuevo obispo.

A lo que añadió: “Hay mucho en juego, tenemos mucho trabajo que hacer. La iglesia debe hacerse ver y escuchar. En el movimiento ecuménico se debate mucho sobre el papel profético de la iglesia; yo opino que se trata de hablar con una voz clara, y de ser tanto críticos como constructivos”.
Tveit insistió en que: “la iglesia, con su mensaje y como actor público, contribuye a la creación y al intercambio de opiniones en la sociedad. En mi desempeño como obispo primado me gustaría contribuir a la visibilidad y la audibilidad de la Iglesia de Noruega, y velar por que sus contribuciones en la esfera pública sean positivas y objetivas”.
El CMI recibe premio Geneva Engage

FUENTE: CMI. Ginebra, Suiza. Enero 30, 2020. El Consejo Mundial de Iglesias (CMI) fue reconocido como una de las principales organizaciones no gubernamentales y quedó en 4º lugar en el certamen Geneva Engage, celebrado el 29 de enero. Este galardón reconoce a los actores de la Ginebra internacional por su alcance en las redes sociales y su compromiso y participación en línea.
El premio fomenta las convergencias en torno al desarrollo, los derechos humanos, los temas relacionados con el mundo digital y otras cuestiones de política entre las comunidades de todo el mundo y la Ginebra internacional, sede de muchas negociaciones internacionales con repercusiones en todos los países y continentes.
“En sus comunicaciones, el CMI se concibe a sí mismo como un catalizador del cambio para un mundo con la unidad, la justicia y la paz en su centro”, afirmó la directora de comunicación del CMI, Marianne Ejdersten. “El CMI se esfuerza por inspirar e invitar a sus iglesias miembros a trabajar juntas, confiriendo activamente una importancia significativa a la voz común de las iglesias”, prosiguió. “Las iglesias miembros son el núcleo del Consejo”.
Los comunicadores del CMI también se esfuerzan por ser incluyentes; su trabajo se basa en la participación y, sobre todo, en la esperanza. “Nuestra tarea es avivar la esperanza de un mundo mejor en el que prevalezca la dignidad humana”, afirmó. “La dignidad y la igualdad humanas deben impregnar todas las comunicaciones”.
“Decir la verdad, incluso cuando es incómoda o no es bienvenida, es una manera poderosa de amplificar las voces que han sido previamente silenciadas, ignoradas, debilitadas o marginadas”, añadió.
Según los estudiantes, venir a Bossey es “difícil”, pero se van sintiéndose “una familia”, sabiendo que “es posible vivir la unidad cristiana”

FUENTE: CMI: Autor: Peter Kenny. Enero 31, 2020. Bossey, Suiza. Los estudiantes recién graduados de Bossey, una localidad enmarcada por las montañas y a orillas del lago de Ginebra, admitieron que la decisión de venir al Instituto Ecuménico del Consejo Mundial de Iglesias (CMI) no fue fácil, pero que se van sintiéndose como una familia, sabiendo que “es posible vivir la unidad cristiana”.
Durante la ceremonia de graduación celebrada el 28 de enero, en la que recibió el Certificado Complementario en Estudios Ecuménicos, el estudiante rumano ortodoxo Alin-Cristian Ivaniciuc leyó un mensaje en nombre de la clase 2019-2020.
“El hecho de tomar la decisión de venir a Bossey fue difícil. Seamos honestos, este lugar es extraño, estamos en medio del bosque, en un lugar remoto”.
No obstante, “a través del diálogo, las clases, las comidas y ayudándonos a confiar los unos en los otros, ustedes nos han demostrado que es posible vivir la unidad cristiana”, dijo Ivaniciuc en nombre de su clase.
“Cada día vivimos la teología ecuménica puesta en práctica en las aulas, en el salón y en la capilla”.
“El grupo más diverso”
Miembros de iglesias de las comunidades locales cercanas y defensores de la unidad cristiana, así como responsables del CMI, asistieron a la ceremonia.
El Rev. Dr. Lawrence Iwuamadi, decano del Instituto Ecuménico, observó: “Desde mi llegada al Instituto en 2012, los estudiantes de la promoción 2019/2020 constituyen el grupo más diverso: 32 estudiantes de 23 iglesias y 19 países, con casi el mismo número de mujeres y hombres”.
Tras un largo período en que la mayoría de los estudiantes venían del Sur Global, dijo, había ahora una representación significativa de alumnos de Europa y Estados Unidos.

Entre los 32 estudiantes que empezaron el año académico en 2019, había diecinueve países representados. Entre estos países, figuraban China, Cuba, Georgia, India, Indonesia, Italia, Kenia, Corea, Madagascar, Nigeria, Rumania, Serbia, Sierra Leone, Sri Lanka, Suecia, Suiza, Tailandia, Ucrania y Estados Unidos.
“El significado más profundo de lo que sucede en Bossey solo se hará patente una vez se hayan marchado. Recuerden, el ecumenismo es una forma de vida. El ecumenismo es real… No tengo dudas de que disponen de los instrumentos necesarios para trabajar por un mundo mejor y por la unidad visible de las iglesias. Ahora que se van de Bossey, les instamos a ser ‘embajadores del amor y la unida’”, dijo Iwuamadi.
Entrega obispo metodista cubano apoyo a la Iglesia Metodista de Puerto Rico por el terremoto del 7 de enero

FUENTE: Facebook de Iglesia Metodista en Puerto Rico. Enero 18, 2020. El Obispo Ricardo Pereira Díaz de la Iglesia Metodista en Cuba solicitó a las 470 iglesias en Cuba y sus 900 misiones que el domingo 12 de enero de 2020 estuvieran en oración por Puerto Rico.
También, que levantaran una ofrenda para ayudar a las víctimas de los terremotos en Puerto Rico, que afectaron esa isla el 7 de enero por la madrugada.
El jueves 16 de enero la Iglesia Metodista en Cuba hizo llegar a las oficinas de la Iglesia Metodista en Puerto Rico un donativo de $ 4,500 (dólares). Los metodistas puertorriqueños expresamos agradecimiento por este acto de amor cristiano de parte de la Iglesia Metodista en Cuba hacia nosotros. Oremos por la Iglesia Metodista en Cuba y por su liderato.
Los evangélicos franceses creen que la nueva ley de bioética pone a los más débiles en manos del mercado y la tecnología
Después de dos años de intenso debate social, el borrador pasa ahora por el Senado. Dos organizaciones evangélicas alertan contra la “tentación de crear una humanidad aumentada”.
FUENTE: Evangelical Focus. Paris, Francia. Febrero 4, 2020. El Senado de Francia ha comenzado las discusiones para examinar la nueva Ley de Bioética, uno de los principales proyectos del presidente Emmanuel Macron, que anunció el plan en 2018 y lanzó una consulta nacional en la que muchos actores de la sociedad civil han dado su opinión.
Cuando el proyecto de ley comenzó su proceso final, los cristianos evangélicos explicaron una vez más sus puntos de vista sobre una norma que regulará la eutanasia, la gestación subrogada y el uso de la inteligencia artificial, entre otros temas. El Consejo Nacional de Evangélicos de Francia (CNEF, por sus siglas en francés) ha manifestado que “quería contribuir a la reflexión nacional”, en la línea del documento Convicciones bioéticas que la entidad evangélica ya había publicado en 2018.
Según el CNEF, “la tentación de crear una ‘humanidad aumentada’ no es nueva, pero este proyecto de ley da una perspectiva a esta tentación que era desconocida hasta ahora”. El Código Penal francés prohíbe cualquier intento de ir en contra de la integridad de los seres humanos y prohíbe las prácticas eugenésicas y otras acciones que “tienden a la organización o selección de personas”, subraya la declaración.
Pero “esa protección antropológica está en riesgo”, dice el CNEF, porque la nueva ley presentada al Senado “elimina cualquier necesidad de autorización para la investigación sobre el embrión”. Una disposición que debería ser retirada, según la entidad evangélica. Con respecto a la procreación asistida, la organización dice que la nueva ley abre un escenario en el que cualquier “proyecto parental bajo demanda” podría aprobarse, posiblemente conduciendo a “los peores excesos de una sociedad técnica de mercado en la que el deseo sería el rey y la ley el sirviente”. Además, “considerar privar a los hijos de los padres sin que sea una cuestión de protección infantil, sería un delito grave contra ellos”, añaden.
La necesaria protección de la libertad de conciencia
El CNEF también aborda lo que dice la propuesta de ley en el área del “respeto a la libertad de pensamiento, de conciencia y de religión, para proteger la pluralidad de opiniones”. Según la entidad, no solo los médicos, sino también otras profesiones deberían tener derecho a la objeción de conciencia, especialmente aquellas áreas profesionales que han visto una rápida evolución tecnológica que ha traído nuevos dilemas éticos. “La ausencia de tales cláusulas conduciría a un efecto disuasorio”, señalan, que podría alienar a las personas con convicciones religiosas o filosóficas de ciertas áreas profesionales de trabajo.
El CNEF concluye su declaración asegurando que, “considerando los riesgos para los seres humanos y para las generaciones que nos seguirán, entendemos y compartimos la preocupación expresada por un gran número de franceses y le pedimos al gobierno, senadores y parlamentarios que estén atentos y escuchen estas voces”.
Cinco millones de personas se manifiestan en Nigeria contra la persecución de los cristianos
Convocada por Asociación Cristiana de Nigeria, la marcha ha puesto fin a tres días de ayuno. Solo en enero han muerto 100 personas por el terrorismo y los enfrentamientos entre musulmanes y cristianos.

FUENTE: Protestante Digital. Nigeria. Febrero 5, 2020. “Los cristianos nigerianos están bajo ataque. Buhari actúa ahora”, o “Nuestros valores y modo de vida prevalecerá, los asesinatos no”. Son algunos de los lemas que hasta cinco millones de personas han exhibido en pancartas este domingo en 28 de las 36 regiones nigerianas, a través de manifestaciones pacíficas contra la persecución religiosa en el país.
Organizadas y convocadas por la interdenominacional Asociación Cristiana de Nigeria (CAN, por sus siglas en inglés), las marchas han puesto punto final a tres días de ayuno y oración que comenzaron como protesta por la decapitación del pastor Lawan Andimi a manos de Boko Haram. “Aunque habíamos protestado antes, este evento ha tomado una nueva dimensión”, ha señalado el presidente de la CAN, Samson Ayokunle en declaraciones a Christianity Today. “A una voz hemos dicho ‘no’ a los asesinatos, ‘no’ a la falta de seguridad, y ‘no’ a la persecución de los cristianos en Nigeria. Es una llamada al gobierno para que despierte”, ha añadido.
Las manifestaciones se han realizado en 28 de los 36 estados en los que se divide la geografía nigeriana.
Solamente en el mes de enero, se han registrado un centenar de asesinatos en Nigeria por causa de ataques terroristas y de los enfrentamientos entre ganaderos musulmanes y agricultores cristianos. “Cuando las personas no están desempeñando los deberes para los que han sido empleadas o designadas, deben dar paso a otros”, ha señalado el director de la CAN en el Estado de Kogi, John Ibenu. “La CAN no tolerará la ineptitud y no guardará silencio porque debemos ser la voz de los que no tiene”, ha remarcado.
La WEA “urge” al gobierno a “poner fin a estos ataques”
La Alianza Evangélica Mundial (WEA, por sus siglas en inglés) también se ha pronunciado contra la violencia que experimentan los cristianos en Nigeria y ha cuestionado la actitud del gobierno. A través de un comunicado firmado por su secretario general, Ephraim Tendero, la entidad recuerda que de los cristianos que han muerto por su fe en todo el mundo durante 2019, el 45% eran nigerianos.
Comienzan los setenta días de la campaña mundial de oración para poner fin a los setenta años de la guerra coreana

FUENTE: CMI. Seúl, Corea. Febrero 6, 2020. Hace setenta años, en la península de Corea estalló una guerra que dividió Corea y que todavía no ha concluido. Por ello, las iglesias del mundo han puesto en marcha la campaña mundial de oración por la paz “Setenta días de oraciones”.
La presentación de la campaña mundial de oración por la paz en la península de Corea se retransmitió el 6 de febrero en directo por Internet desde el Consejo Mundial de Iglesias (CMI) en Ginebra. El mismo día se realizaron actos similares en Washington D. C. y también en Seúl, más temprano.
“En este año, 2020, se conmemora el 70 aniversario del comienzo de la guerra de Corea. ¡Setenta años! Los coreanos del norte y del sur han vivido con dolor y odio durante mucho tiempo”, dijo el secretario general del CMI, Rev. Dr. Olav Fykse Tveit, en un mensaje durante la presentación en Ginebra de la campaña de oración.
“Durante este período de oración, las iglesias de todo el mundo escucharán las desgarradoras historias de aquellos que han pasado por el sufrimiento de la división. Conocerán asimismo a las personas que ya han vivido vidas de reconciliación y de paz más allá de la división”.
Tveit aseguró que, desde la celebración de la X Asamblea del CMI en Busan en 2013, el CMI ha renovado y fortalecido su compromiso de aumentar los esfuerzos ecuménicos por la paz, la reconciliación y la reunificación del dividido pueblo coreano.
El Rev. Dr. Jin Yang Kim, encargado de programa del CMI y coordinador adjunto del Foro Ecuménico para Corea, dio comienzo al acto golpeando un característico gong a la manera coreana, y el cantante coreano Baekeun Cho ofreció una conmovedora interpretación del Agnus Dei.
Reemplazar el armisticio por un tratado de paz
“Aspiramos sinceramente a poner fin a la guerra de Corea, declarando el reemplazo del Acuerdo de Armisticio por un tratado de paz”, dijo Tveit.

Durante la campaña, que se desarrollará del 1 de marzo al 15 de agosto, cientos de miles de personas del mundo entero dirán: “¡Oramos porque haya paz ahora y termine la guerra!”.
La guerra de Corea que dividió al país en dos tuvo lugar de 1950 a 1953, pero los combates cesaron solo con un armisticio, y aún no se ha firmado un tratado de paz. Se cree que al menos tres millones de personas han muerto en los enfrentamientos y muchas familias fueron separadas por la división del país.
Se invitó a los representantes de la Federación Cristiana Coreana de la República Popular Democrática de Corea y del Consejo Nacional de Iglesias de la República de Corea a reflexionar sobre el significado de setenta años y compartir sus esperanzas de cara al futuro.
La campaña hizo un claro llamado a una península coreana desnuclearizada como parte de un mundo libre de armas nucleares.
“La división continuada desde 1945 y la inacabada guerra de Corea de 1950 se han convertido en un ‘pecado original’ socio-geopolítico contra la seguridad vital del pueblo coreano”, dijo el Rev. Dr. Hong-Jung Lee, secretario general del Consejo Nacional de Iglesias de Corea.
